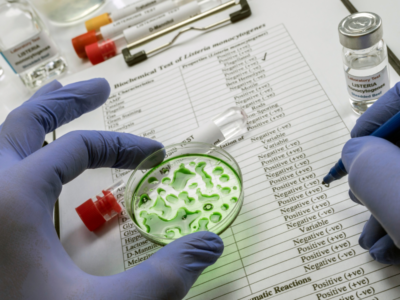

-

We need maximum glycerol levels for all foods and drinks
08 May 2026
This must include de-alcoholised drinks....
-

SAFE calls for consumers to follow recommendations on cereulide crisis
27 Feb 2026
SAFE Food Advocacy Europe takes note of the joint rapid outbreak assessment (ROA) on cereulide contamination in infant formula and calls for European consumers to follow its recomm...
Tags: baby formula, Cereulide, EFSA
-

EU imposes new toxin threshold following worldwide infant formula recalls
04 Feb 2026
The European Food Safety Authority (EFSA) has introduced a new maximum safe daily intake level for cereulide, a toxin produced by Bacillus cereus. This decision follows recalls of ...
Tags: Cereulide, EFSA, Infant formula, Threshold
-

Empowering consumers, EFSA launches the 2024 Safe2Eat Campaign
13 May 2024
EFSA, alongside its EU Member State partners, reintroduces a revitalised effort to promote food safety throughout Europe with its 2024 Safe2Eat campaign. This campaign builds upon ...
Tags: Education, EFSA, Food Safety
-

Antimicrobial resistance, insights from EFSA and ECDC report
05 Mar 2024
The report issued by the European Food Safety Authority (EFSA) and the European Centre for Disease Prevention and Control (ECDC) highlights the ongoing challenge of antimicrobial r...
Tags: Consumers, EFSA, Food Safety
-

Food contaminated with inorganic arsenic: health risks confirmed
25 Jan 2024
The European Food Safety Authority’s (EFSA) recent risk assessment on inorganic arsenic in food reaffirms the findings of a previous study from 2009, confirming health risks ...
Tags: Consumers, EFSA, European Commission, Food Safety
-
Listeria outbreak linked to fish products raises concerns, EFSA says
05 Jan 2024
A multi-country outbreak of listeria monocytogenes, which has impacted Austria, Belgium, Italy, Germany and the Netherlands between the years of 2022 and 2023, has been attributed ...
Tags: EFSA
-

EFSA created TKPlate, a platform for predicting the toxicity of chemicals without animal testing
24 Nov 2023
The European Food Safety Authority (EFSA) annouced the launch of TKPlate, a groundbreaking initiative in the realm of food safety that seeks to revolutionise traditional practices ...
Tags: chemicals, EFSA, Risk Assessment
-

No majority for glyphosate. SAFE confirms its opposition to the renewal
13 Oct 2023
The re-approval of the controversial herbicide glyphosate in the EU did not secure a majority decision in its first vote in the European Parliament today (October 13), highlighting...
Tags: EFSA, European Commission, European Parliament, Glyphosate
-

The EU sets revised guidelines for nitrates and nitrites
10 Oct 2023
In pursuit of utmost food safety within the European Union and as a proactive measure under Europe’s Beating Cancer Plan, the European Commission has established revised guid...
Tags: Additives, Consumers, EFSA, European Commission, nitrates, nitrites
-

The European Commission proposes re-approval of glyphosate for 10 years
21 Sep 2023
The European Commission has put forth a proposal to grant a 10-year extension for glyphosate. The contentious chemical substance stands as the most widely utilised pesticide across...
Tags: Agriculture, Consumers, EFSA, European Commission, Pesticides
-

Bisphenol A present in the bodies of nearly all Europeans
19 Sep 2023
The European Environment Agency reported that Bisphenol A (BPA), a chemical known for its potential to disrupt hormones and commonly used in food packaging, has been found in the b...
Tags: bisphenol A, EFSA, European Environment Agency, microplastics
-

EFSA has re-evaluated the risk of exposure to mineral oil hydrocarbons through food
14 Sep 2023
The European Food Safety Authority (EFSA) announced that it has re-evaluated the risk assessment of mineral oil hydrocarbons (MOH), substances derived primarily from crude oil, but...
Tags: EFSA, Food Safety, mineral oil hydrocarbons, MOH
-

Glifosato, l’Ue prepara l’ok – Altolà di Safe: è pericoloso
19 Jul 2023
...
Tags: EFSA, European Commission, Glyphosate
-

EFSA launches public consultation on toxic food contaminants PBDEs
19 Jun 2023
The European Food Safety Authority (EFSA) launched a public consultation on health risks associated with polybrominated diphenyl ethers (PBDEs) in food. According to the draft scie...
Tags: BFRs, EFSA, Food Safety, PBDEs
-

EFSA, nitrosamines in food raise health concerns
29 Mar 2023
According to the assessment conducted by EFSA on the health risk associated with the presence of nitrosamines in food, these compounds may pose a health concern for consumers. Ten ...
Tags: EFSA, Food Safety, nitrates, Nitrosamines
-

EFSA, mineral oil hydrocarbons in food are a “potential health concern”
21 Mar 2023
While the European Food Safety Authority (EFSA) provisionally confirmed that some substances in the group know as mineral oil aromatic hydrocarbons (MOAH) are a possible health con...
Tags: EFSA, Food Safety, mineral ol hydrocarbons
-

EU Commission authorises two genetically modified crops as food and animal feed
22 Feb 2023
The European Commission has authorised the use of genetically modified rapeseed and has renewed the authorisation for genetically modified soy, intended for human and animal consum...
-

Total copper intakes below new safe level, EFSA says
20 Jan 2023
The European Food Safety Authority (EFSA) has established a new acceptable daily intake (ADI) for copper and assessed that the combined exposure to copper from all sources doe...
Tags: copper, EFSA, Food Safety
-

PFAS: European Commission adopts new rules against dangerous contaminants in food
07 Dec 2022
The European Commission adopted new rules to protect citizens against chemicals that can have negative consequences on the immune system, the development of foe...
Tags: EFSA, Food Safety, PFAS
-

New RAC assessment on the risks of glyphosate
03 Jun 2022
On May 30th, The Risk Evaluation Committee (RAC) from ECHA published the conclusions of its assessment on the various risks of glyphosate. Based on hundreds of feedbacks from vario...
Tags: ECHA, EFSA, Glyphosate, Pesticides
-

Recent call to reform the pesticides evaluation system.
17 Mar 2022
In a recent video, MEP Eric Andrieu, points out the shortcomings in the current pesticide evaluation system. Highlighting that the current situation induces a great health risk, wh...
Tags: EFSA, European Parliament, Pesticides
-

Acrylamide in food: the urgent need to reform the current legislation
10 Mar 2022
Acrylamide is a chemical compound generated during high-temperature cooking processes that transform sugar and amino acids present in food products. For many years the scientific c...
Tags: Acrylamide, EFSA, European Commission, Food Safety
-

Regulatory challenges: the case of E171 in the EU and the UK
10 Feb 2022
Titanium dioxide, also known as E171 is an additive very commonly used as a white colourant in food, but also in many other products, e.g., paints, cosmetics, toothpaste, etc. ...
Tags: E171, EFSA, Food Additives, titanium dioxide, UK
-

EFSA draft opinion suggests lowering the tolerable Bisphenol A daily intake
22 Dec 2021
In an opinion published in December 2021, the European Food Safety Agency (EFSA) has re-assessed the risks of bisphenol A (BPA) in food, suggesting to drastically lower the tolerab...
Tags: bisphenol A, BPA, EFSA, FCM, food contact materials
-

New French study on the harmfulness of food additives for human health
17 Nov 2021
Food additives are substances intentionally added to foodstuffs for various technological, sensory, and nutritional purposes (e.g. extending shelf life, sweetening, or stabilizing ...
-

E171 ban decision confirmed in the SCoPAFF
08 Oct 2021
On 8 October 2021, the Standing Committee on Plant, Animal, Food and Feed voted in favour of a proposal submitted by the European Commission to ban food additive E 171 (Titanium di...
Tags: E171, EFSA, European Commission, ScoPAFF, titanium dioxide
-

European Commission redefines maximum levels for cadmium and lead in food
12 Aug 2021
On August 10th, the European Commission announced that new limits will apply for tolerated lead and cadmium levels in food products. These restrictions concern fruits, vegetables, ...
Tags: cadmium, EFSA, European Commission, food contact materials, lead
-

MEPs follow up on EFSA’s opinion regarding E171
31 May 2021
On 31 May 2021, a group of 4 MEPs from 3 different groups asked the Commission about its intent to propose an EU-wide ban on food additive E171 (titanium dioxide). It is still uncl...
Tags: E171, EFSA, European Parliament, ScoPAFF, titanium dioxide
-

E171 no longer considered safe for use as a food additive
06 May 2021
On 6 May 2021, The European Food Safety Authority (EFSA) published its long-awaited safety assessment of titanium dioxide (TiO2) used as a food additive (E171)[1]. The assessment c...
Tags: E171, EFSA, Scientific Opinion, titanium dioxide
-

EFSA also enters the Front-of-Pack nutrition labelling debate
08 Feb 2021
The EU food safety agency EFSA will provide scientific opinions to help developing the EU-wide system for front-of-pack nutrition labelling of foodstuffs, including setting conditi...
Tags: EFSA, European Commission, Front-of-Pack nutrition labelling, Nutrient profiles
-

European Ombudsman asks Commission to increase transparency in the approval process for pesticides
14 Dec 2020
In a recently published decision, the EU Ombudsman has raised concerns regarding the current procedure for the approval of active substances in pesticides by the Commission. The pr...
Tags: Agriculture, EFSA, European Commission, European Ombudsman, Pesticides, Transparency
-

European Commission publishes its chemicals strategy
14 Oct 2020
The EC published its new Chemicals Strategy on the 14th October (read it here). The EU chemicals strategy aims to address the cumulative and combined effects of chemicals, includin...
Tags: chemicals, EFSA, European Commission, green deal, Pesticides
-

Transparency on Risk Assessment in the Food chain: SAFE’s response to Public Consultation
25 Aug 2020
SAFE replied to a Public Consultation on the Draft Implementing Regulation amending Regulation (EU) No 234/2011 on EU Transparency on risk assessment in the food chain on 25 August...
Tags: EFSA, independent research, Public Consultation, Risk Assessment, Transparency
-

New EFSA opinion on welfare hazards in pig slaughters
24 Jun 2020
The European Food Safety Authority (EFSA) published a scientific opinion on 17 June in the context of a series of updated assessments on animal welfare at slaughter requested by th...
Tags: animal welfare, EFSA, European Commission, Farm to Fork, pigs
-

EFSA report offers snapshot into pesticide residues on food
11 Apr 2020
The European food supply chain and food safety system are proving to be extremely resilient, according to Europe’s People Party (EPP) coordinator at European ParliamentR...
Tags: EFSA, Food Safety, Pesticides
-

EFSA chief: EU food safety rules ensure protection against COVID-19
07 Apr 2020
Although coronavirus can survive on surfaces for a limited time, food safety regulations in EU member states ensure a high level of protection against contaminated food, said the c...
Tags: covid-19, EFSA, Food Safety
-

Commissioner Kyriakides respond to 34 MEPs’ letter on E171
23 Jan 2020
On 17 December 2019, a cross-party coalition of 34 MEPs sent a letter to Health and Food Safety Commissioner Stella Kyriakides to ask for an extension of the French ban on the whit...
Tags: DG SANTE, E171, EFSA, Food Additives, Food Safety, health, MEP
-

EFSA extends its deadline to give an opinion on added sugars
23 Jul 2019
The European Food Safety Authority (EFSA) has delayed the release of its opinion concerning added sugar until 2021. As obesity, type 2 diabete, tooth decay or cardiovascular diseas...
Tags: cardiovascular diseases, diabete, EFSA, Obesity, SAFE, Scientific Opinion, Sugar, tooth decay
-

Divided opinions about the French ban on E171
27 Jun 2019
A recent evaluation of titanium dioxide in food from the French national food safety agency ANSES belied EFSA’s assessment of this substance. The evaluation highlighted significa...
Tags: E171, EFSA, Food Additives, Food Safety, France, titanium dioxide
-

Recycled plastics: ‘There will always be a risk’
03 Sep 2018
Until now, companies have stayed away from using recycled plastics in food packaging because of safety concerns. But times are chaning and they seem ready to reconsider their stan...
-

Listeria monocytogenes: update on foodborne outbreak
06 Jul 2018
Frozen corn and possibly other frozen vegetables are the likely source of an outbreak of Listeria monocytogenes that has been affecting Austria, Denmark, Finland, Sweden, and the...
Tags: Consumers, EFSA, Food Safety
-

New guidance on nanotechnologies in food and feed
04 Jul 2018
EFSA has published its guidance on how to assess the safety of nanoscience and nanotechnology applications. The guidance focuses on the safety assessment for human and animal healt...
Tags: Additives, EFSA, Food Packaging, Food Safety, Pesticides
-

Pesticide residues: new advice on foods for infants and young children
28 Jun 2018
Following a request from the European Commission, EFSA has made a number of recommendations to further protect young infants from potential risks posed by pesticide residues in foo...
Tags: Babies, Consumers, EFSA, Food Safety, Pesticides
-

Les agences européennes précisent la définition des perturbateurs endocriniens
12 Jun 2018
Après l’adoption fin 2017 des critères d’identification des perturbateurs endocriniens, les agences européennes ont publié le 7 juin un document d’orientation pou...
Tags: EFSA, Endocrine disruptors, EU, Food Safety
-

Fipronil: results of follow-up monitoring published
07 May 2018
On 3 May 2018, EFSA published its analysis of food data collected following the widespread detection of fipronil in eggs last summer. The analysis showed that 742 out of 5,000 samp...
Tags: Consumers, EFSA, Fipronil, Food Safety
-

EU Commission wants new powers to vet product safety
12 Apr 2018
On April 11, the European Commission proposed giving itself new powers to request scientific studies on the safety of products, in an effort to quell public concerns that industry ...
Tags: Consumers, EFSA, European Commission, Food Safety, Glyphosate, GMO, Monsanto, Pesticides, Roundup
-

Public consultation: sugars in food
10 Jan 2018
EFSA is seeking feedback on the approach it plans to take for its upcoming assessment of dietary sugars. The aim of the assessment is to establish a cut-off value for intake of “...
-

Six member states call for glyphosate alternatives, exit plan
05 Jan 2018
Six member states that opposed the re-authorisation glyphosate, the world’s most commonly used weedkiller, sent a letter to the European Commission last month asking the EU execu...
Tags: Agriculture, ECHA, EFSA, Endocrine disruptors, Environment, European Commission, European Parliament, Food Safety, Glyphosate, GMO, Member States, Monsanto, Pesticides, Roundup
-

Is Glyphosate safe? We have the right to know
16 Dec 2017
By Emilia Korkea-aho and Päivi Leino In November 2017, after a great deal of political maneuvering, the EU Member States decided to extend authorization for glyphosate, the world�...
Tags: Consumers, EFSA, European Parliament, Glyphosate, MEP, Pesticides, Roundup

Tag: EFSA

-
Rue Vilain XIIII, 17 / Vilain XIIII Straat, 17
1050 Brussels
Belgium
B.C.E. : 0578.909.064
Tel:+32 (0) 2 898 38 38 SAFE – Safe Food Advocacy Europe is financially funded by the European Union in the framework of the ESF+ Operating Grant. Views and opinions expressed are those of Safe Food Advocacy Europe only and do not necessarily reflect those of the European Union or the European Commission. Neither the European Union nor the granting authority can be held responsible for them
ESF-2021-OG-NETW-NGO-SGA
Copyright © 2026 SAFE | Privacy Policy | Cookie Notice | Developed by ALYS

